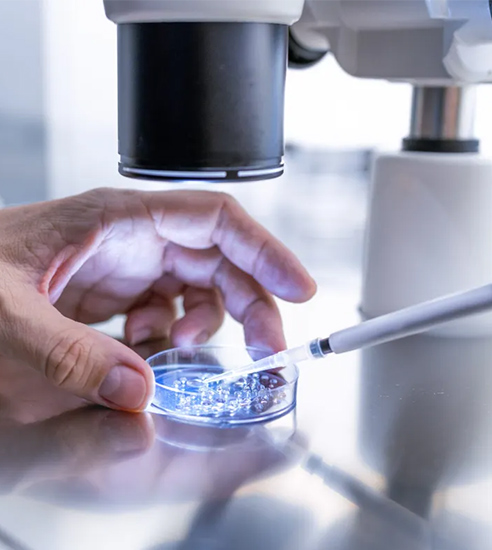

Welcome to Blossoms Fertility Center, your premier fertility treatment clinic in Bandlaguda Jagir, Hyderabad, where compassionate care meets advanced reproductive technology. Recognized as the best fertility hospital in Hyderabad, we specialize in personalized IUI fertility treatment for couples seeking parenthood.
As a leading fertility center in Bandlaguda Jagir, we provide expert guidance, state-of-the-art diagnostics, and tailored treatment plans designed to maximize your chances of a successful pregnancy. From women fertility treatment clinic services to assisted reproductive therapies, our fertility treatment specialist Dr. Afshan Anjum ensures that every patient receives safe, evidence-based, and compassionate care.

Successful fertility treatment begins with a thorough assessment. At Blossoms, our fertility evaluation services include

IUI, or intrauterine insemination Hyderabad, is one of the most effective and minimally invasive fertility treatments offered at Blossoms. Our IUI fertility treatment Hyderabad includes

In addition to IUI, Blossoms provides a wide range of assisted reproductive treatment Bandlaguda Jagir services, including

As a dedicated women fertility treatment clinic, Blossoms offers comprehensive fertility care services Hyderabad, including

At Blossoms Fertility Center, patient comfort and safety are paramount. Our facility is equipped with






Our fertility treatment specialist in Bandlaguda Jagir, Dr Afshan Anjum, has years of experience managing complex infertility cases and performing IUI procedures with precision and care.
From hormonal assessment for fertility to ultrasound scans and semen analysis, our fertility evaluation Hyderabad ensures a complete understanding of your reproductive health.
Every couple’s journey is unique. Our Fertility care specialist, Dr. Afshan Anjum designs personalized fertility plans that address specific challenges, increasing the chance of successful conception.
As a leading IUI fertility center, Blossoms is equipped with advanced labs, imaging facilities, and monitoring technology to deliver safe, effective, and precise treatments.
We prioritize emotional support and patient education, making your fertility journey comfortable, transparent, and stress-free.
Blossoms offers round-the-clock assistance for all fertility-related concerns, making us a trusted fertility treatment clinic in Bandlaguda Jagir, Hyderabad.

Safe, minimally invasive procedure for women with unexplained infertility
Comprehensive assessment for women and men
Ensuring optimal reproductive health
ovulation induction follicular imaging and Hormonal therapy.
Counseling, emotional support, and lifestyle recommendations
Pregnancy confirmation and early-stage support.

After years of struggling with infertility, Blossoms gave us hope. We underwent IUI treatment here, and the team guided us with compassion and expertise at every step. Today, we are blessed with a healthy baby boy, all thanks to Dr.Afshan Anjum

Hyderabad

Hyderabad

Hyderabad

Hyderabad
When couples face delays in conceiving, a proper medical evaluation can help uncover the reasons early. At Blossoms, couples receive a complete assessment at a trusted fertility evaluation clinic Hyderabad, where doctors carefully review both partners’ medical history and reproductive health. With guidance from an experienced fertility consultation specialist Bandlaguda Jagir, the team identifies possible concerns and suggests suitable next steps to improve the chances of conception.
A fertility consultation is the first step toward understanding reproductive health. At our fertility consultation hospital Hyderabad, doctors discuss previous medical records, menstrual cycles, lifestyle factors, and any earlier treatments. A qualified reproductive health specialist Bandlaguda Jagir may recommend specific diagnostic tests to understand the underlying cause of infertility and guide couples toward the right treatment plan.
Couples who have been trying to conceive for several months without success may benefit from visiting a fertility testing hospital in Hyderabad. Early evaluation by an experienced infertility consultation expert Bandlaguda Jagir can help identify hormonal imbalances, ovulation issues, or male fertility concerns. Detecting these factors early often helps doctors begin treatment sooner and improve pregnancy outcomes.
A thorough assessment at our reproductive diagnostic centre Hyderabad includes several important tests that help doctors understand reproductive health. These may involve hormonal blood tests, pelvic ultrasound scans, ovulation monitoring, and semen analysis. An experienced infertility evaluation specialist Bandlaguda Jagir reviews the results carefully and explains the most suitable fertility treatment options.
IUI is a commonly recommended fertility procedure offered at our IUI treatment hospital Hyderabad. During this treatment, specially prepared sperm is placed directly inside the uterus during the ovulation period to increase the chances of fertilization. The procedure is supervised by an experienced IUI fertility specialist Bandlaguda Jagir, ensuring precise timing and careful monitoring throughout the process.
Couples dealing with mild fertility challenges may benefit from treatment at a best IUI fertility clinic Hyderabad. Conditions such as ovulation problems, mild sperm abnormalities, or unexplained infertility can often be managed effectively through this procedure. A qualified insemination treatment expert Bandlaguda Jagir evaluates each case carefully before recommending IUI as a suitable option.
The success of IUI depends on several factors, including age, fertility condition, and proper ovulation timing. At our IUI success centre Hyderabad, the treatment cycle is closely monitored to improve pregnancy chances. Under the supervision of an experienced fertility procedure specialist Bandlaguda Jagir, doctors track ovulation and ensure the procedure is performed at the most effective time.
Some couples may require advanced medical support to achieve pregnancy. At our Assisted reproductive treatment hospital Hyderabad, specialized procedures are offered to help couples overcome complex fertility challenges. A trained ART specialist Bandlaguda Jagir evaluates the couple’s reproductive health and recommends suitable treatments based on their diagnosis and medical history.
Couples who continue to face difficulty conceiving even after initial treatments may need advanced care at an advanced fertility treatment centre Hyderabad. An experienced reproductive medicine expert Bandlaguda Jagir carefully reviews previous reports, treatment history, and medical conditions before recommending suitable assisted reproductive procedures that can improve the chances of conception.
Yes, every couple receives individualized care at our personalized fertility treatment hospital Hyderabad. The doctors understand that fertility challenges can differ for each couple, so treatments are carefully tailored to their medical condition. A dedicated fertility planning specialist Bandlaguda Jagir creates a customized treatment strategy designed to give couples the best possible opportunity to conceive.

At Blossoms Fertility Center, we combine advanced medical expertise with compassionate care to support women and families at every stage of life.